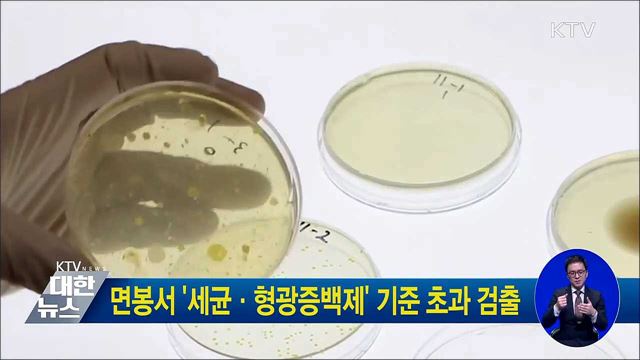
면봉서 '세균·형광증백제' 기준 초과 검출

본문


KTV 대한뉴스
"KTV는 내일도 국정운영의 바른 소리를 전달하겠습니다"
KTV는 국정운영 홍보채널로서 정부 정책을 신속하고 정확하게 국민에게 전달하는 것을 기관의 중요 목적으로 한다. 이에 KTV 대한뉴스는 공공의 이익에 기반 한 정확한 보도를 생명으로 한다. VCR물은 미디어 환경 변화에 민감하게 반응하여 이용자에게 소구하며 만족감을 주는 완성도 높은 콘텐츠를 제작한다.
더불어 심미적 화면 구성으로 뉴스 프로그램의 품질 완성도를 높인다.
[본방송] 월~금요일 19시 00분
[재방송] 월~금요일 22시 00분
프로그램내 인기영상
인기뉴스
- 종량제봉투 대란조짐? 사실은 [정책 바로보기]
- 공공부문 차량 5부제 강화···반복 위반 시 징계
- 고용부 "지방정부 감독·수사 전문성있고 적법하게 이루어지도록 준비 철저" [정책 바로보기]
- 과기부 "오창 다목적 방사광 가속기 구축, 지연되지 않도록 최선" [정책 바로보기]
- 이 대통령 "제주 4.3 최악의 국가폭력범죄···끝까지 책임"
- 공공부문 차량 5부제 강화···반복 위반 시 징계
- "중동 상황, 오일쇼크 수준···생필품 수급 선제 대응"
- '지방 의대 정원' 2027년 대폭 증가한다···"지역의사제 본격 도입"
- 제주서 타운홀미팅···"탄소중립 선도·에너지 대전환"
- "살던 곳에서 맞는 노후"···지역사회 통합돌봄

![김포공항 [뉴스링크]](/media/contents/image/2018/11/07/q8Rf2Ht1Ap.jpg)
![국정상설협의체와 협치의 시작 [유용화의 오늘의 눈]](/media/contents/image/2018/11/07/2NU9hB4Nmm.jpg)
![겨울철 미세먼지로부터 건강을 지키는 방법 [똑똑한 정책뉴스]](/media/contents/image/2018/11/07/bofa2VC4yI.jpg)








